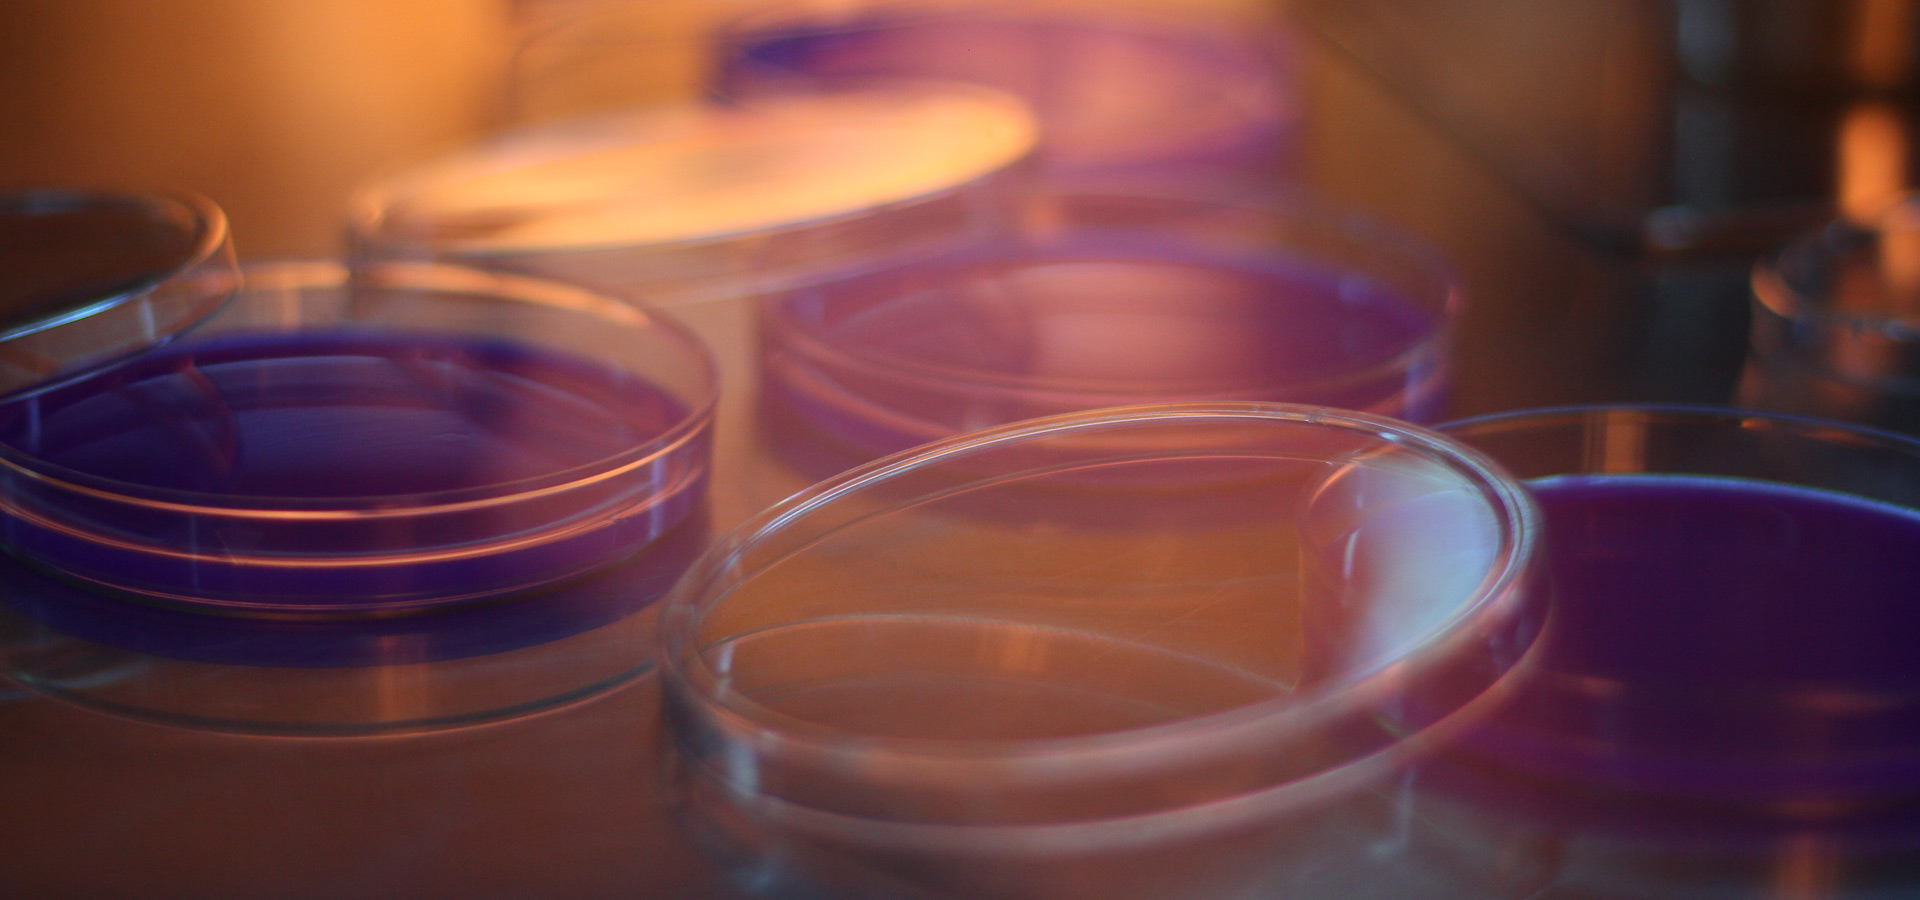
Image
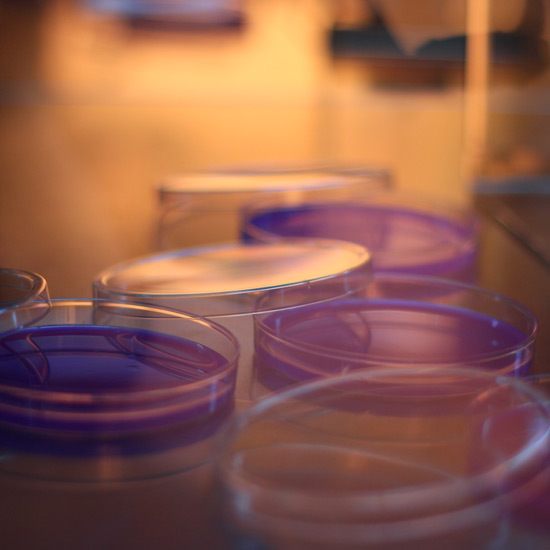

Research & Academic Support
Explore More

Expert Scientific Team
Explore More
Our Collaborators
MARIGENOME proudly collaborates with leading institutions and organizations to strengthen research, innovation, and scientific development.



Recognitions
MARIGENOME is proudly recognized and supported by prestigious institutions and government bodies for its contribution to research, innovation, and scientific development.

Founded with a vision to advance affordable and accessible life science research, Marigenome is proudly incubated at CUSAT TBI fostering innovation in molecular biology, microbiology, aquaculture, and biotechnology.

Marigenome is a proud recipient of the prestigious PMMSY grant, recognizing its commitment to innovation and excellence in fisheries, biotechnology, and life science research. Affiliated with the Department of Fisheries Kerala Marigenome continues to support sustainable aquatic research, advanced molecular analysis, and student-driven scientific initiatives across Kerala.

Marigenome is a DPIIT-recognized Startup India venture with a focus on affordable scientific solutions and research-driven excellence, and industry-oriented applications across the life sciences sector.
MARIGENOME
Marigenome, established with the support of the Pradhan Mantri Matsya Sampada Yojana (PMMSY) and the Department of Fisheries, Kerala, is a leading research and training hub dedicated to bridging the gap between academia and industry. We specialize in delivering advanced solutions across fisheries, aquaculture, molecular biology, microbiology, and allied scientific domains.
To strengthen the research ecosystem by developing industry-ready professionals equipped with technical expertise, critical thinking, and problem-solving skills. Through the integration of science, technology, and innovation, we create sustainable solutions that deliver measurable impact.
Our Services
Provides a diverse range of services catering to both academic and industrial needs, with a strong emphasis on molecular biology and microbiology. Our solutions are designed to support researchers, students, and industries in achieving their goals through cutting-edge, reliable methodologies.
At Marigenome, we leverage cutting-edge molecular and microbiological techniques to support innovative research across diverse scientific disciplines. Our comprehensive services are designed to meet the rigorous demands of modern research, offering expertise in both wet lab and bioinformatics domains.


● Our state-of-the-art laboratory facilities are available with flexible, on-demand rental options tailored to meet the unique needs of students, academic researchers, and industry professionals.
● Featuring dedicated microbiology and molecular biology labs, advanced instrumentation, and expert technical support, our labs offer a fully equipped environment ideal for high-impact research, development, and innovation.

● We provide water and chemical testing services for fish farms, factories, schools, businesses, and even homes!!!!
● Our modern lab gives accurate and trustworthy results, so you can be confident your water is safe to use and meets health and environmental rules!!!


● Ensure the integrity and safety of food products with our advanced molecular testing services.
● We specialize in food authentication and fraud detection using cutting-edge molecular techniques such as DNA barcoding, PCR (Polymerase Chain Reaction), and real-time PCR.
Connect with Us
Our Achievements

Receiving Kairali Research Award 2024 From Shri. Pinarayi Vijayan, Chief Minister Of Kerala State And Dr. R. Bindu, Minister For Higher Education & Social Justice

Govt. of Kerala